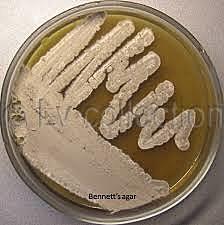
Tetraciclina

-
Etanol, Butanol, Acetona, Glicerol
Ácidos orgánicos- Ácido cítrico
Tratamiento aerobio de aguas residuales -
Alexander Fleming aísla la penicilina de un cultivo Penicillium notatum
-
William Cumming Rose. Descubrió el aminoácido treonina, y su investigación determinó la necesidad de aminoácidos esenciales en la dieta y los requisitos mínimos diarios de todos los aminoácidos para un crecimiento óptimo.
-
Penicilinas
Gran variedad de antibióticos
Tecnología de la estructura de la célula animal: vacunas contra virus
Transformaciones microbiológicas de esteroides -
Producción de penicilina en cultivo sumergido por P. chrysogenum en biorreactores
-
Albert Schatz descubrió la estreptomicina. Es un antibiótico bactericida de espectro pequeño, derivado de la actinobacteria Streptomyces griseus.
-
Benjamin Minge Duggar descubrióla primera tetraciclina, la clorotetraciclina (aureomicina) a partir de un cultivo de Streptomyces aureofaciens
-
La primera cefalosporina fue aislada de cepas del hongo Cephalosporium acremonium de una alcantarilla en Cerdeña por el científico italiano Giuseppe Brotzu. Él notó que estas cepas producían una sustancia eficaz contra la salmonela, Salmonella typhi.
-
Se descubrió la glucosa 6 fosfato isomerasa, una enzima intracelular que se origina a partir de microorganismos diferentes, por ejemplo de Streptomyces.
-
Gasohol
Glucosa Isomerasa
Enzimas (detergentes) -
-
Woese y George E. Fox reconocen las archeas como el tercer dominio de los seres vivos
-
Gracias al trabajo conjunto de investigadores de la firma Genentech Inc. logran sintetizar la insulina humana
-
Hopwood y col. realizaron la secuenciación del genoma de Streptomyces coelicolor. Bacterias que producen numerosos antibióticos de uso clínico de origen natural
-
Se secuencia el genoma del Saccharopolyspora erythraea, el microorganismo productor del antibiótico eritromicina
-
Se descubre el proceso de esporulación en Mycobacterium, bacteria de importancia médica
-
Se descubrió que Bacillus subtilis puede producir dos esporas en la misma célula madre. Es una bacteria cosmopolita presente en numerosos hábitats y resulta ser un excelente agente de control biológico de enfermedades causadas por hongos de suelo y bacterias.